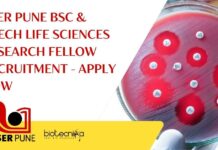
IISER Pune BTech Life Sciences Job

Home 2024
Yearly Archives: 2024
Govt Central Silk Board BSc & MSc Life Sciences Project Job – Attend Walk-In-Interview
Govt Silk Board Project Job Opening - BSc & MSc Life Sciences Eligible
CENTRAL SERICULTURAL RESEARCH AND TRAINING INSTITUTE
CENTRAL SILK BOARD, MIN.OF TEXTILES, GOVT.OF INDIA
MANANDAVADI...
Project Associate Opportunity at IIT Kanpur For Life Sciences – Apply Now
IIT Kanpur Life Sciences Project Job Opening - Apply Now
INDIAN INSTITUTE OF TECHNOLOGY KANPUR
ADVERTISEMENT
Department of Biological Sciences & Bioengineering
Advertisement Number: P.Rect./R&D/2024/164
Applications are invited from...
Cancer Research Project Associate Post at Tata Memorial Centre! Attend Walk-In
Cancer Research Project Associate Post at Tata Memorial Centre! Attend Walk-In
TATA MEMORIAL CENTRE
ADVANCED CENTRE FOR TREATMENT, RESEARCH AND EDUCATION IN CANCER
Kharghar, Navi Mumbai- 410...
VIT Vellore ICMR Funded Life Sciences & Biotech Research Fellow Recruitment – Apply Now
VIT Vellore Biotech Research Recruitment - Apply Now
Job Description:
Applications are invited for the Post of Junior Research Fellow (JRF) for the Indian Council of...
IISER Pune BSc & BTech Life Sciences Research Fellow Recruitment – Apply Now
IISER Pune BTech Life Sciences Job - Applications Invited From BSc
Advertisement No.: 34/2024
Purely on Temporary and Contractual Basis
The Indian Institute of Science Education and...
Pfizer Microbiology Job Opening – Apply Online For Associate Role
Pfizer Microbiology Job Opening - Apply Online For Associate Role
Associate-Microbiology
Locations: India - Vizag
Time type: Full time
Posted on: Posted Today
Job Requisition...
Hybrid Life Sciences Pharmacovigilance Specialist Job Opening at Clarivate, Apply Online
Life Sciences Pharmacovigilance Specialist Job Opening at Clarivate, Apply Online
Pharmacovigilance Specialist
Location: Noida, Uttar Pradesh, India
Category: Life Sciences & Healthcare
Remote: Hybrid
Job...
Cytiva Microbiology Scientist Job – Life Sciences Apply Online
Cytiva Microbiology Scientist Job - Life Sciences Apply Online
Scientist I
Cytiva Karnataka,
Karnataka, India
Category: Science
Job Id: R1268029
Location: Karnataka, India
At Cytiva you...
Biotecnika Times Newsletter 19.06.2024 – Exclusive Walk-In-Drive at Reliance Life Sciences, Govt PMBI Biotech...
Govt of India Dept of Pharma PMBI Biotech Jobs - Applications Invited
Explore biotech job openings at PMBI for BSc and MSc graduates. Applications are...
NII Delhi MSc, MTech Life Sciences Research Fellow Recruitment – Apply Now
Life Sciences Research Job at NII Delhi - Applications Invited
NATIONAL INSTITUTE OF IMMUNOLOGY
ARUNA ASAF ALI MARG
NEW DELHI
Applications are invited for the one position of...
Pfizer Microbiology Associate Job – Candidates With 1 Year Exp Can Apply Online
Pfizer Microbiology Associate Vacancy - Candidates With 1 Year Exp Can Apply Online
Associate - Microbiology
Locations: India - Vizag
Time type: Full time
Posted on: Posted Today
Job...
NIMHANS Project Jobs With Rs. 56,000 pm Pay – Life Sciences, Biotech & Biochem...
NIMHANS Project Vacancies With Rs. 56,000 pm Pay - Life Sciences, Biotech & Biochem Apply
NATIONAL INSTITUTE OF MENTAL HEALTH AND NEURO SCIENCES
(INSTITUTE OF NATIONAL...
Presidency University MSc Biology, Biochem & Biophysics Research Position – Applications Invited
Presidency University MSc Biology, Biochem & Biophysics Research Position - Applications Invited
Advertisement for one Junior Research Fellow position in SERB sponsored research project at...
Amrita School of Nanosciences and Molecular Medicine Hiring! Life Sciences Apply For JRF Post
ASNSMM Life Sciences JRF Job Opening - Applications Invited
ASNSMM IS HIRING!
Junior Research Fellowship
Amrita School of Nanosciences and Molecular Medicine (ASNSMM), Amrita Vishwa Vidyapeetham, Kochi...
Exclusive Hiring Walk-In-Drive for Women Workforce at Reliance Life Sciences!
Reliance Life Sciences Walk-In For Women - Biotech, Microbiology, Biochem Eligible
WALK-IN DRIVE FOR WOMEN
Reliance Life Sciences
We welcome women returning to workforce post a career...